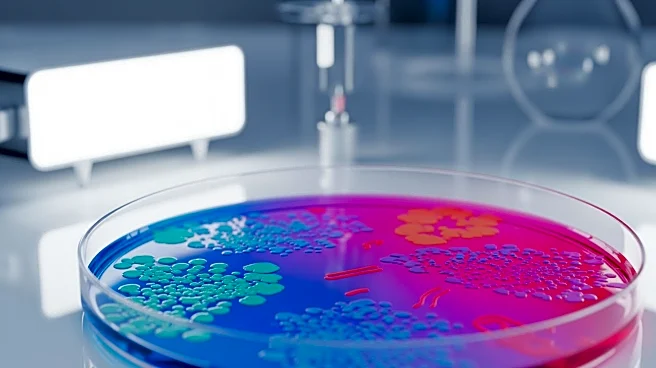
MaaT Pharma to Present Key Data on Microbiome Therapies at EBMT Annual Meeting

What's Happening?
Jonathan Aranda, an All-Star first baseman for the Tampa Bay Rays, played a pivotal role in Mexico's 8-2 victory over Great Britain in the opening game of the World Baseball Classic in Houston. Aranda, who was previously an unknown rookie during the 2023
Classic, has since become a key player for Team Mexico. His performance included a crucial two-out, three-run homer in the eighth inning, which broke a 1-1 tie and set the stage for Mexico's win. Team Mexico manager Benji Gil praised Aranda as a potential MVP candidate, highlighting his growth and impact on the team. The game saw Mexico struggle offensively until Aranda's decisive hit, which was followed by a strong ninth inning to secure the win.
Why It's Important?
Aranda's performance underscores his development from a reserve player to a central figure in international baseball, reflecting the broader trend of emerging talent in the sport. His ability to deliver under pressure not only boosts Team Mexico's prospects in the tournament but also enhances his reputation in Major League Baseball. This victory is significant for Mexico as it sets a positive tone for their World Baseball Classic campaign, potentially increasing their chances of advancing in the tournament. For Aranda, this game could further solidify his status as a rising star, attracting attention from fans and scouts alike.
What's Next?
Following this victory, Team Mexico will look to build on their momentum in the upcoming games of the World Baseball Classic. The team's performance will be closely watched as they aim to progress through the tournament. For Aranda, continued strong performances could lead to further accolades and opportunities within MLB. The team's success could also inspire increased support and interest in baseball within Mexico, potentially influencing the sport's development in the region.